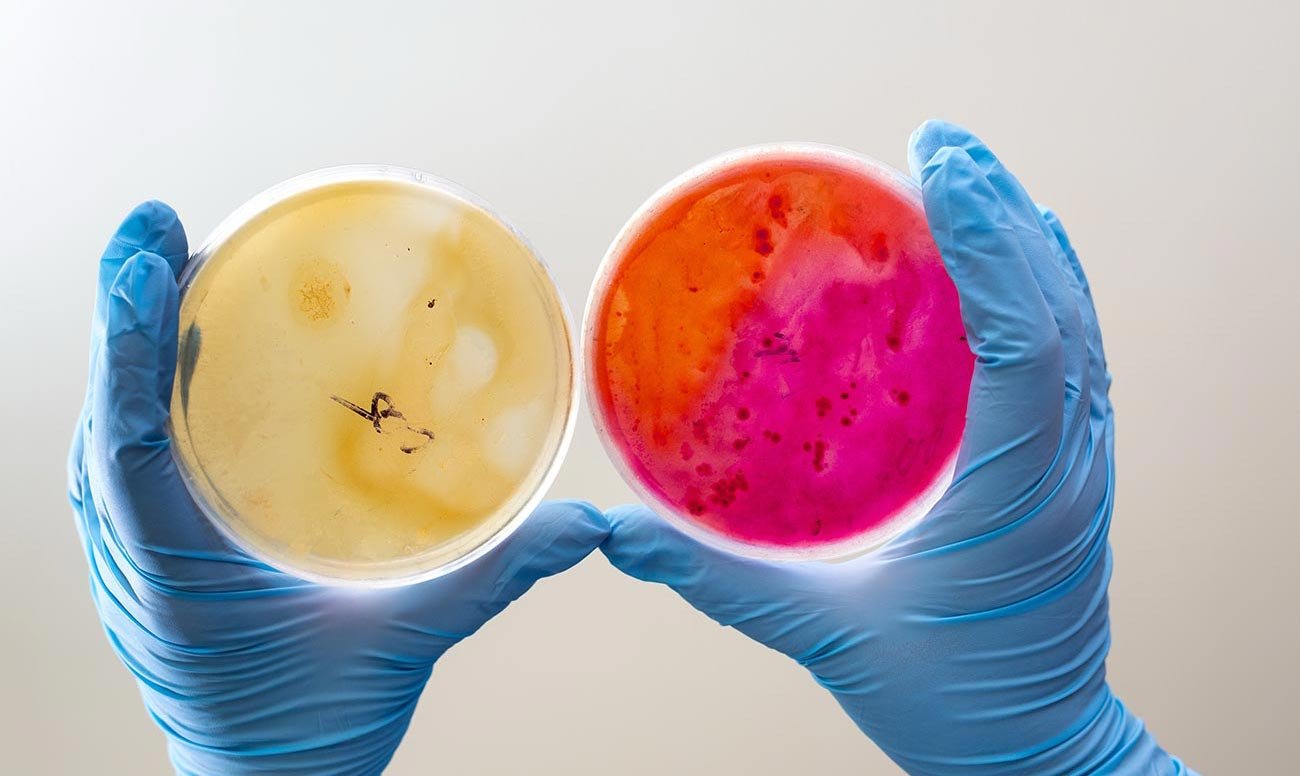

Your Health, Our Mission
Ut wisi enim ad minim veniam, quis laore nostrud exerci tation ulm hedi corper turet ipsum dolor sit amet, consectetuer adipiscing elit, sed diam nonummy nibh euismod tincidunt ut laoreet dolore magna aliquam erat volutpat. Ut wisi enim ad
Amazing Technology
Ut wisi enim ad minim veniam, quis laore nostrud exerci tation ulm hedi corper turet ipsum dolor sit amet, consectetuer adipiscing elit, sed diam nonummy nibh euismod tincidunt ut laoreet dolore magna aliquam erat volutpat. Ut wisi enim ad
Achieving Better Health
Ut wisi enim ad minim veniam, quis laore nostrud exerci tation ulm hedi corper turet ipsum dolor sit amet, consectetuer adipiscing elit, sed diam nonummy nibh euismod tincidunt ut laoreet dolore magna aliquam erat volutpat. Ut wisi enim ad
Medical Research
Ut wisi enim ad minim veniam, quis laore nostrud exerci tation ulm hedi corper turet ipsum dolor sit amet, consectetuer adipiscing elit, sed diam nonummy nibh euismod tincidunt ut laoreet dolore magna aliquam erat volutpat. Ut wisi enim ad